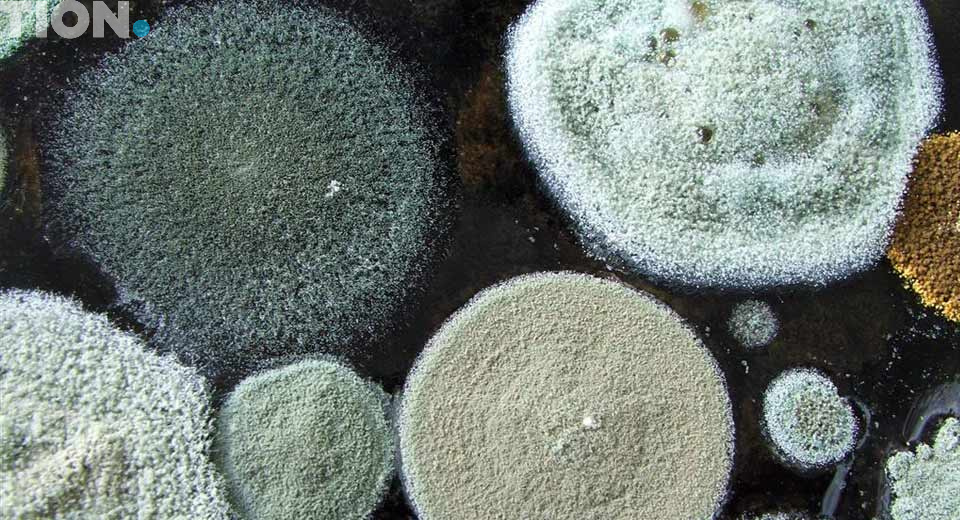
Причины появления в квартире плесени
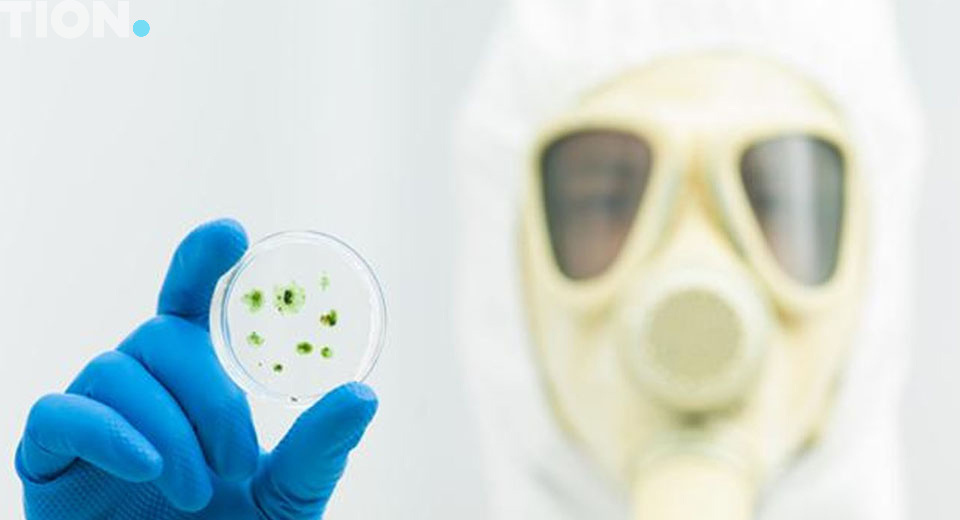
Виды плесени

Где обычно вырастает домашняя плесень
Часто на деревянных материалах. Целлюлоза – основной источник пропитания домовых грибов. И чтобы добраться до нее, грибок способен прорасти даже сквозь бетон и кирпич. Обработка временными антисептиками спасает на несколько месяцев, после этого на стенах опять могут появиться пятна плесени.
Из-за вредных грибков древесина гниет и растрескивается. На отделанных стенах могут появиться выпуклости, может упасть штукатурка, отшелушиться краска или лак, часто отслаиваются обои. В особо тяжелых случаях может посыпаться кирпич. Также страдают перекрытия и фундамент, через них гриб тоже может прорастать.
Когда появляется плесень в квартире
Мелкие споры грибов переносятся по воде или воздуху, обычно на небольшие расстояния. Какое-то время споры могут храниться в земле. В дом споры могут попасть сотней способов: на одежде и обуви, через окно, через вытяжку от соседей, с продуктами, дачными вещами и так далее. И если в доме благоприятные для них условия, грибы начнут расти в нем.
Благоприятных условий для развития плесени в квартире пять:
- Сыро: влажность в районе 70-80% и выше
- Тепло: температура не ниже 20°С
- Плохо работает естественная вентиляция: воздух не движется, и споры могут спокойно оседать
- Неравномерный нагрев воздуха: на стыке тепла и холода конденсируется влага
- Мало солнечного света
Плесень прорастает там, где особенно сыро, темно и куда воздух из окна почти не попадает. Обычно это стены и потолки в ванной комнате, нижние и верхние углы в комнатах, район стены возле батареи, где разница температур особенно большая.
Как распознать конкретный вид грибка
Прежде всего, не всегда надо определять конкретный вид плесневого или домового гриба. На ранних стадиях развития почти все грибки удаляются стандартными методами: механической очисткой со специальным средством от плесени в квартире и обработкой антисептиком длительного срока действия. В этом деле можно обойтись и без анализа грибков.
Анализ имеет смысл в двух случаях:
- Кто-то из членов семьи болеет аллергией на конкретный вид плесени
- Грибок в таком запущенном состоянии, что нужно особое сильнодействующее средство от плесени определенного типа
Есть специальные комплекты для самостоятельного определения вида плесени. Стоят они несколько тысяч рублей, а их надежность анализа под сомнением. Лучше обратиться к специалисту, причем из лицензированной лаборатории с хорошими отзывами.
Приводить описание всех специализированных противогрибковых средств незачем: хороший специалист после анализа сам посоветует Вам наиболее подходящий антисептик. Однако, как мы уже сказали, в большинстве случаев можно обойтись универсальными средствами от плесени в квартире. Ниже короткие описания основных из них.
Универсальные средства от плесени в квартире
Atlas Mykos
Этот концентрат удаляет плесневые, домовые грибки, водоросли, лишайники и мох. Для обработки древесины надо развести в пропорциях 1:2, для минеральных поверхностей – 1:5. Использовать можно как внутри помещения, так и снаружи.
Astonish
Эффективное средство от черной плесени. Пятна со стен удаляются даже без выскабливания. Если надо почистить оконные рамы, пластиковые душевые кабинки, занавески, плитку или бетон в ванной, смело покупайте этот препарат.
SZAVO
Известное средство от плесени в квартире, особенно во влажных местах: на кухне, в санузлах, бассейнах, банях и саунах, а также цокольных этажах и технических помещениях. Полностью убивает грибницу плесени, дрожжевых грибков и даже водорослей. Использование элементарное: никакой предварительной подготовки и смывать не надо. Средство просто высыхает, причем без разводов и пятен.
Belinka
Еще один известный «убийца» грибков. Это средство широкого спектра, хотя изначально создавалось как средство именно от плесени и грибков. Belinka на водной основе, перед использованием производитель рекомендует развести препарат водой в пропорциях 1:4. Годится и для внутренней, и для внешней отделки.
Antialga B25
Тоже средство на водной основе, содержит противогрибковые вещества: альгицин и фунгицид. Эффективно борется с различными видами плесневых и домовых грибов. Основная фишка этого средства – низкая токсичность и никакого запаха. Часто добавляется в краски для дополнительной защиты древесины.
Well Done
Средство от плесени нового поколения. Имеет дополнительный антибактериальный эффект. Результат видно почти сразу после обработки. Обычно используется для антисептической обработки поражённых участков древесных материалов, штукатурки и покрашенных стен, а также окон, вентиляционных систем и санузлов.
Снежка Пропитка
Известное противогрибковая пропитка. В первую очередь, для древесины, в том числе со штукатурной отделкой и малярным покрытием. Можно использовать и для внутренних, и для наружных работ.
Борамон С30
Антисептик для древесины, в том числе оштукатуренной и покрашенной. Защищает не только от грибков, но и от бактерий и даже насекомых (личинок термитов, короедов и прочих). Особенность в том, что Борамон составляет с древесиной постоянное соединение. При этом степень ее возгораемости остается прежней.
Mellerud
Аэрозольное средство от плесени. Распыляете – и грибки, водоросли и бактерии умирают мгновенно. Расход около 500 мл на 5-8 квадратных метров. Можно использовать для керамической плитки, межплиточных швов, стен из камня, дерева и искусственных материалов.
Schimmelentferner Dufa
Еще один аэрозоль для быстрого уничтожения плесени и других биологических чужеродных образований на стенах. На водной основе, содержит хлор. Годится для внутренних и наружных работ.
Заключение
Конечно, приведенный обзор неполный. Вы можете выбрать средство от плесени не из этого списка. В любом случае, перед покупкой прочитайте аннотацию к этому антисептику и поймите, а точно ли он подходит для Ваших целей. И обязательно соблюдайте все указания в инструкции.
Кроме обработки стен антисептиком, нужно устранить первопричины появления плесени в квартире: высокая влажность и недостаток воздухообмена. Это можно сделать с помощью приточной вентиляции – она понизит влажность и усилит рециркуляцию воздуха в квартире.
Подробнее о профилактике появления грибков и их влиянии на здоровье напишем в следующий раз.

0 Комментариев